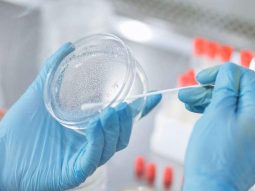
{{brizy_dc_image_alt entityId=

Sempre più studi confermano che il cosiddetto jet lag sociale, ovvero il disallineamento tra il nostro orologio biologico interno e gli impegni sociali o lavorativi, può avere ripercussioni significative sul sistema immunitario. Sentirsi confusi, irritabili o semplicemente stanchi dopo aver dormito poco o in orari irregolari non è solo un problema passeggero. A lanciare l’allarme è un team dell’Università di Auckland, che ha individuato un legame diretto tra ritmo circadiano disturbato e maggiore vulnerabilità alle infezioni.
Table of Contents
Cos'è il jet lag sociale e perché è diverso da quello da fuso orario
Il jet lag sociale non ha nulla a che vedere con i viaggi intercontinentali. Si verifica quando i nostri orari di sonno-veglia variano sensibilmente tra i giorni lavorativi e il weekend, o in generale quando non si dorme in modo regolare. Questo squilibrio provoca un vero e proprio disallineamento tra il ritmo circadiano, ovvero l’orologio interno del corpo, e gli orari esterni imposti da turni, impegni o abitudini sbagliate.
Il risultato è una condizione cronica che va ben oltre la semplice stanchezza: il corpo entra in uno stato di stress, con effetti negativi su vari apparati, compreso quello immunitario.
Quando l'orologio biologico si scontra con la vita moderna
Viviamo in una società che ci spinge a essere attivi a ogni ora del giorno e della notte. Ma i nostri meccanismi interni non sono progettati per funzionare così. Il ritmo circadiano si è evoluto per permetterci di funzionare al meglio durante il giorno e riposare durante la notte. Alterare costantemente questa armonia – ad esempio dormendo poco nei giorni feriali e recuperando ore di sonno nel weekend – manda in tilt i sistemi di regolazione interna.
La ricerca neozelandese spiega che questa alterazione è collegata a un indebolimento delle risposte immunitarie, aprendo la porta a infezioni batteriche e virali.
Neutrofili: le prime cellule immunitarie a risentirne
I protagonisti dello studio sono stati i neutrofili, un tipo di globuli bianchi fondamentali nella lotta contro i batteri. Analizzando il comportamento di queste cellule nei pesci zebra – scelti per le loro somiglianze con l’uomo a livello genetico e biologico – i ricercatori hanno scoperto che la loro efficienza nel combattere i patogeni varia nel corso della giornata.
Durante le ore diurne, quando gli animali sono più attivi, i neutrofili mostrano una capacità superiore di riconoscere e distruggere i batteri. Di notte, invece, questa funzione cala notevolmente. Il motivo? Le cellule immunitarie hanno un loro orologio interno regolato dalla luce, che indica loro quando essere più attive.
Un meccanismo di difesa evolutivo
La scoperta suggerisce che l'organismo umano – così come quello di molte altre specie diurne – ha sviluppato una strategia di difesa che si attiva nelle ore in cui è più probabile entrare in contatto con agenti patogeni. Essere biologicamente “pronti” di giorno è un vantaggio evolutivo che si perde nel momento in cui stravolgiamo il nostro ciclo sonno-veglia.
Ecco perché chi lavora su turni notturni o vive con ritmi irregolari presenta una maggiore incidenza di malattie infettive: il sistema immunitario si ritrova fuori fase proprio nei momenti in cui dovrebbe essere più reattivo.
Il potenziale per nuove terapie farmacologiche
Lo studio apre anche la strada allo sviluppo di nuove strategie terapeutiche: se i neutrofili funzionano meglio quando sono sincronizzati con l’orologio circadiano, farmaci mirati a potenziare questo meccanismo potrebbero rafforzare le difese immunitarie.
Il team dell’Università di Auckland sta infatti esplorando la possibilità di agire farmacologicamente sul clock biologico delle cellule immunitarie, per ottimizzare la risposta dell’organismo a infezioni o infiammazioni.
Il ruolo della luce nel regolare le difese
Il collegamento tra luce naturale e sistema immunitario è uno dei punti chiave della ricerca. L’esposizione alla luce del giorno è il principale regolatore del ritmo circadiano, e dunque anche dell’efficienza immunitaria. Quando questo stimolo viene meno – ad esempio per chi passa gran parte del tempo in ambienti chiusi o lavora di notte – l’intero sistema entra in uno stato di disorientamento.
Gli studiosi stanno ora cercando di capire esattamente come i neutrofili “percepiscono” la luce e se questo meccanismo sia presente anche negli esseri umani. L’obiettivo è chiarire se esistono differenze tra la risposta a batteri notturni o diurni e come potenziare le difese nel momento giusto.
Visite specialistiche mirate e prevenzione: i rischi del jet lag sociale

Mantenere un ritmo circadiano regolare è oggi una delle strategie più efficaci per sostenere il sistema immunitario. Chi accusa sintomi come stanchezza cronica, difficoltà di concentrazione, irritabilità o infezioni ricorrenti, dovrebbe considerare una valutazione clinica specifica: un medico può consigliare controlli del sonno, dosaggi ormonali (come melatonina o cortisolo), o consulenze con specialisti in cronobiologia.
Una prevenzione efficace passa anche da piccoli accorgimenti quotidiani: andare a dormire e svegliarsi sempre alla stessa ora, ridurre l’esposizione alla luce artificiale di sera, e assicurarsi una dose adeguata di luce naturale durante il giorno.
Sincronizzarsi con la natura per stare meglio
Non si tratta solo di dormire abbastanza. La chiave sta nel dormire in modo coerente con il proprio orologio biologico. Secondo i ricercatori, i ritmi circadiani si sono evoluti oltre due miliardi di anni fa proprio per aiutare gli esseri viventi a sopravvivere alle sfide del ciclo giorno-notte.
Nella nostra era fatta di turni, notti in bianco e maratone su streaming e social, riscoprire questa armonia potrebbe essere una delle scelte più efficaci per proteggerci dalle malattie.